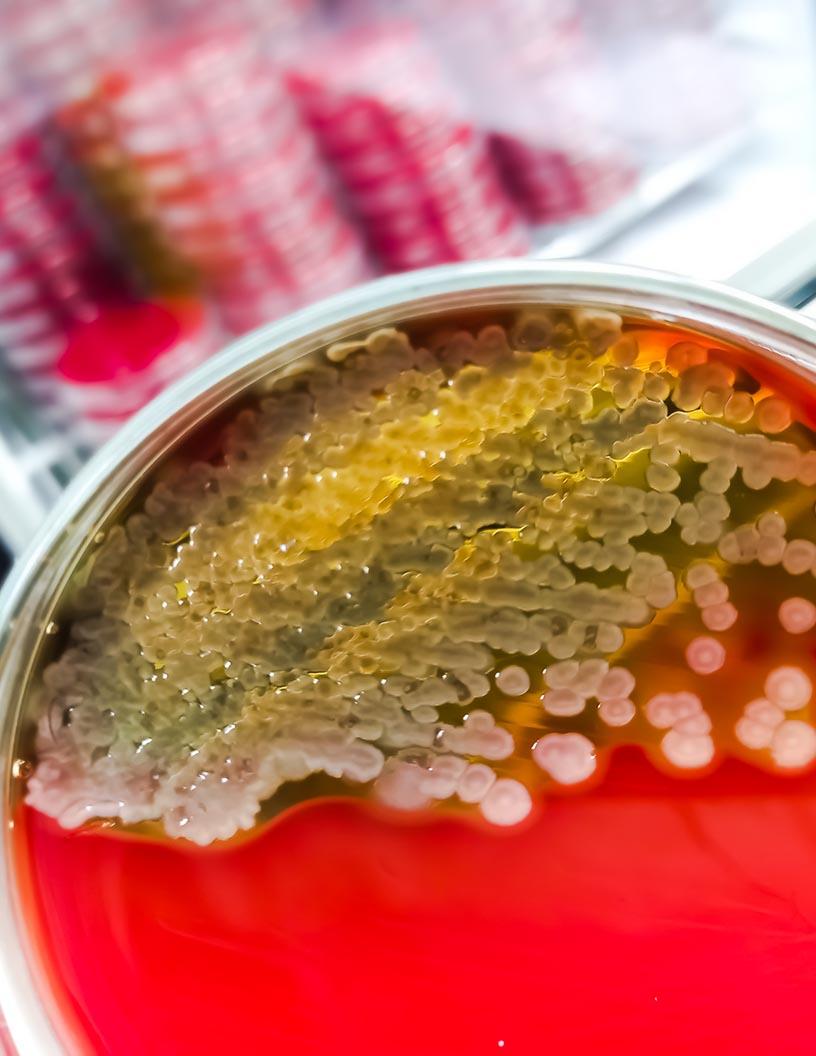
Animal Biotechnology Market Analysis North America, Europe, Asia, Rest of World (ROW) - US, Germany, Canada, China, UK, Brazil, France, Japan, Australia, India - Size and Forecast 2025-2029

Biotechnology Market Research Reports
{{ totalResults }} reports found
for "{{ selecteCategory }}"
No results found

Non-alcoholic Steatohepatitis (NASH) Market Analysis, Size, and Forecast 2026-2030:
North America (US, Canada, and Mexico), Europe (Germany, UK, and France), APAC (China, Japan, and India), Middle East and Africa (UAE, South Africa, and Saudi Arabia), South America (Brazil), Asia, Rest of World (ROW)
North America (US, Canada, and Mexico), Europe (Germany, UK, and France), APAC (China, Japan, and India), Middle East and Africa (UAE, South Africa, and Saudi Arabia), South America (Brazil), Asia, Rest of World (ROW)
The Non-alcoholic Steatohepatitis (NASH) Market size is expected to grow by USD 40056.2 million from 2026-2030 expanding at a CAGR of 47.1% during the...

Human Platelet Lysate Market Analysis, Size, and Forecast 2026-2030:
North America (US, Canada, and Mexico), Europe (Germany, France, and UK), APAC (China, Japan, and India), South America (Brazil, Argentina, and Colombia), Middle East and Africa (Saudi Arabia, South Africa, and UAE), Asia, Rest of World (ROW)
North America (US, Canada, and Mexico), Europe (Germany, France, and UK), APAC (China, Japan, and India), South America (Brazil, Argentina, and Colombia), Middle East and Africa (Saudi Arabia, South Africa, and UAE), Asia, Rest of World (ROW)
The Human Platelet Lysate Market size is expected to grow by USD 12123.6 million from 2026-2030 expanding at a CAGR of 3.7% during the forecast period...

Global AI In Nanotechnology Market Analysis, Size, and Forecast 2025-2029:
North America (US, Canada, and Mexico), APAC (China, Japan, and India), Europe (Germany, UK, and France), Middle East and Africa (Saudi Arabia, UAE, and South Africa), South America (Brazil, Argentina, and Colombia), and Rest of World (ROW)
North America (US, Canada, and Mexico), APAC (China, Japan, and India), Europe (Germany, UK, and France), Middle East and Africa (Saudi Arabia, UAE, and South Africa), South America (Brazil, Argentina, and Colombia), and Rest of World (ROW)
The Global AI In Nanotechnology Market size is expected to grow by USD 12867.4 million from 2025-2029 expanding at a CAGR of 19.3% during the forecast...

Wound Care Biologic Market Analysis, Size, and Forecast 2025-2029:
North America (US, Canada, and Mexico), Europe (Germany, UK, and France), APAC (China, Japan, and India), South America (Brazil), Middle East and Africa (Saudi Arabia, UAE, and South Africa), Asia, Rest of World (ROW)
North America (US, Canada, and Mexico), Europe (Germany, UK, and France), APAC (China, Japan, and India), South America (Brazil), Middle East and Africa (Saudi Arabia, UAE, and South Africa), Asia, Rest of World (ROW)
The Wound Care Biologic Market size is expected to grow by USD 701.3 million from 2025-2029 expanding at a CAGR of 5.5% during the forecast period....

Whole Exome Sequencing Market Analysis, Size, and Forecast 2025-2029:
North America (US, Canada, and Mexico), Europe (Germany, UK, and France), APAC (China, Japan, and India), South America (Brazil), Middle East and Africa (UAE, South Africa, and Saudi Arabia), Asia, Rest of World (ROW)
North America (US, Canada, and Mexico), Europe (Germany, UK, and France), APAC (China, Japan, and India), South America (Brazil), Middle East and Africa (UAE, South Africa, and Saudi Arabia), Asia, Rest of World (ROW)
The Whole Exome Sequencing Market size is expected to grow by USD 3742.8 million from 2025-2029 expanding at a CAGR of 21.1% during the forecast perio...

Bovine Colostrum Market Analysis, Size, and Forecast 2025-2029:
North America (US, Canada, and Mexico), Europe (Germany, France, and UK), APAC (China, India, and Japan), South America (Brazil), Middle East and Africa (UAE, Saudi Arabia, and South Africa), Asia, Rest of World (ROW)
North America (US, Canada, and Mexico), Europe (Germany, France, and UK), APAC (China, India, and Japan), South America (Brazil), Middle East and Africa (UAE, Saudi Arabia, and South Africa), Asia, Rest of World (ROW)
The Bovine Colostrum Market size is expected to grow by USD 607.3 million from 2025-2029 expanding at a CAGR of 5.6% during the forecast period....